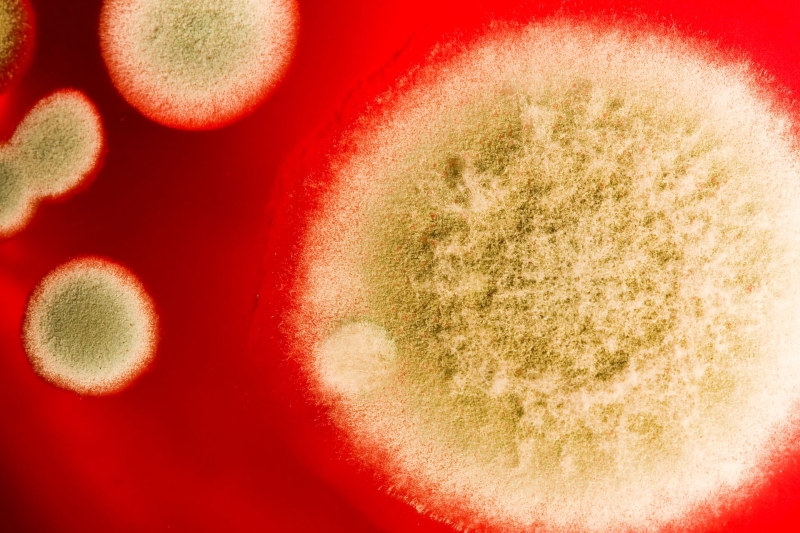
Смертельная "русская матрешка": выявлена новая инфекционная угроза

Машина скорой помощи
Летальность высокая, а избавиться труднее, чем от бактерий, — ВОЗ признала грибковые инфекции критической проблемой. И ситуация ухудшается: лекарства уже не дают эффекта. К тому же, как выяснилось, плесень действует не одна, а в плотной связке с вирусами. Кто в зоне риска и как снизить угрозу — в материале РИА Новости.
Теперь и в Европе
Хотя мы вдыхаем потенциально вредоносные споры едва ли не каждый день, грибковые инфекции, в отличие от вирусных или бактериальных, в общественном сознании остаются чем-то экзотическим или даже фантастическим. Так, в последние годы популярность снискала компьютерная игра Last Of Us и снятый по ее мотивам сериал, где показан зомби-апокалипсис, спровоцированный мутировавшим грибом — кордицепсом. К счастью, пока представители царства Fungi не научились превращать людей в ходячих мертвецов и подчинять своей воле. Однако есть и печальные новости: некоторые виды плесени действительно становятся все опаснее для человека.
Грибок Aspergillus fumigatus ежегодно вызывает около 2,1 миллиона случаев инвазивного аспергиллеза и 1,8 миллиона хронических инфекций легких. Показатель летальности от инвазивной формы достигает крайне высоких 30-80 процентов, что делает его одним из наиболее опасных грибковых патогенов, сообщает Всемирная организация здравоохранения.
Особую тревогу вызывает растущая устойчивость к противогрибковым препаратам, например к азолам, которые широко используются в медицине и сельском хозяйстве. В некоторых регионах резистентность достигает 15-20%, а в образцах из окружающей среды в Азии — свыше 80%. И показатели быстро увеличиваются. Причем не только в экзотических странах, но и в Европе.

Сотрудница микробиологической лаборатории
В ходе недавней работы Медицинский центр нидерландского Университета Радбауд и Института общественного здоровья RIVM проанализировал более 12 000 мазков, собранных из легких пациентов за 30 лет. В образцах Aspergillus fumigatus, взятых в 1994-м, ученые не обнаружили грибков, устойчивых к лекарствам. Первую мутацию, вызывающую резистентность, выявили в 2000 году, а в 2009-м — еще одну. На сегодняшний же день в коллекции центра накоплено более 12 000 изолятов A. fumigatus, которые демонстрируют четкий рост устойчивости.
Помимо двух основных мутаций, за 30 лет у грибка возникли многочисленные мелкие изменения в ДНК, которые могут появляться в различных комбинациях. «Сегодня мы имеем около двух тысяч устойчивых штаммов, 17% из которых демонстрируют вариации в мутациях резистентности», — поясняет первый автор исследования Пол Вервей, медицинский миколог. Эти разные штаммы почти всегда присутствуют у пациентов в смешанной форме, что делает терапию все более сложной.
Кто управляет
Ситуация осложняется тем, что грибок действует не один: возбудитель аспергиллеза может нести в себе вирус A. fumigatus Polymycovirus-1 (AfuPmV-1M). Новое исследование показало, что этот патоген, по-видимому, дает грибку несколько ключевых преимуществ для выживания.
В работе, опубликованной в журнале Nature Microbiology, ученые исследовали мышей, зараженных A. fumigatus , который, в свою очередь, был инфицирован вирусом AfuPmV-1M. Такую конструкцию ведущий автор Марина Кампос Роча, научный сотрудник Еврейского университета в Иерусалиме, сравнила с «русской матрешкой». Использованный грибок был первоначально выделен из легкого пациента, умершего от аспергиллеза.
Как выяснилось, когда мышам давали противовирусные препараты, выживаемость грызунов повышалась. В их легких наблюдалось меньше грибковой инфекции, а уровень вируса снижался по сравнению с мышами, которые лекарство не получали.
Грибковая плесень
Грибки, подвергшиеся воздействию противовирусных препаратов, размножались менее эффективно и демонстрировали снижение выработки меланина; у многих болезнетворных грибков меланин повышает вирулентность и способность выживать в суровых условиях.
При этом, как отметила Роча, сам вирус не может причинить вред мышам или человеку, поскольку ему нужны специфические рецепторы и белки для связывания, а у млекопитающих они отсутствуют. Каждый вирус, вызывающий грибковые инфекции, обычно специфичен для одного вида грибов, добавила она.
Исследователи предполагают, что вирус помогает процветанию грибка, контролируя некоторые процессы, посредством которых грибок перерабатывает РНК — генетическую молекулу, участвующую в синтезе белков. Вирус каким-то образом улучшает реакцию на стресс и синтез белка, тем самым повышая его выживаемость в неблагоприятных условиях. В ходе работы выяснилось, что иммунным клеткам человека стало сложнее уничтожать инфицированные вирусом штаммы грибка по сравнению с неинфицированными.
Авторы исследования признают: это лишь первый шаг к пониманию того, как инфекция работает на молекулярном уровне.
«С ними еще сложнее”
Проблема грибковых инфекций — вопрос неоднозначный, рассуждает в беседе с РИА Новости ведущий инженер кафедры микологии и альгологии биологического факультета МГУ Максим Дьяков.
«С одной стороны, по идее, угроза должна расти. Происходит глобальное потепление, и ареалы в том числе грибных флор двигаются на север. С другой, в тропических зонах, где за счет температур опасность заражения выше, не наблюдается какого-то массового бедствия», — говорит ученый.
Здоровый организм легко справляется с грибковой инфекцией. Чтобы она приобрела характер тяжелого заболевания, должно сойтись несколько факторов, объясняет он. Во-первых, антисанитария, которая позволила бы выделиться большому количеству спор. Во-вторых, иммунитет должен быть ослаблен — либо в результате тяжелой болезни, либо, например, на фоне пересадки органов, когда его подавляют искусственно.
Один из редких случаев массового заболевания грибковой инфекцией произошел в Индии в разгар COVID-19. Плесень росла на стенах переполненных лечебниц, как «свиная щетина», и легко поражала истощенные вирусом организмы, продолжает Дьяков.
«А вот развитие устойчивости у грибов — действительно серьезная проблема, аналогичная устойчивости к антибиотикам у бактерий. Однако с грибами бороться еще сложнее, так как они эволюционно ближе к человеку, и сложнее создать препарат, который убивал бы их, не вредя пациенту», — объясняет миколог.
Тем не менее, отмечает он, решением этой проблемы сейчас занимаются лаборатории по всему миру, в том числе в России. Поэтому «грибной пандемии» бояться пока не стоит. Не говоря уже о зомби-апокалипсисе.